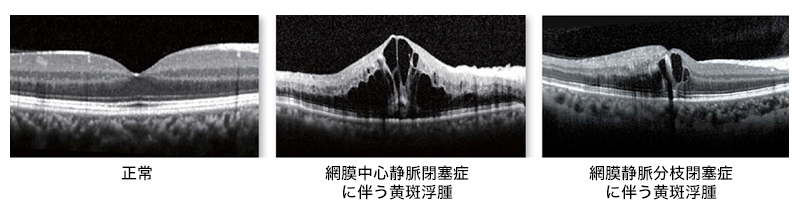

網膜硝子体疾患、最新の白内障手術なら札幌中央区の眼科 おくしば眼科へ
おくしば眼科
〒060-0011札幌市中央区北11条西14丁目1-1ほくやくビル2F
| 診療時間 | 月 | 火 | 水 | 木 | 金 | 土・日・祝 |
|---|---|---|---|---|---|---|
| 9:00〜12:00 | ● | ● | ● | ● | ● | 休 |
| 14:00〜17:00 | ● | 手術 | ● | - | ● | 休 |
ご予約はこちら 011-707-8181 011-707-8186
診療内容 -網膜静脈閉塞症-

おくしば眼科
〒060-0011札幌市中央区北11条西
14丁目1-1 ほくやくビル2F
(1Fにパルス薬局がございます)
011-707-8181 011-707-8186

| 診療時間 | 月 | 火 | 水 | 木 | 金 |
|---|---|---|---|---|---|
| 9:00〜 12:00 | ● | ● | ● | ● | ● |
| 14:00〜 17:00 | ● | 手術 | ● | - | ● |
※土日祝は休診となりますので、ご了承ください。

診療のご案内

・網膜静脈閉塞症について
網膜静脈閉塞症は、網膜の動脈と静脈の交叉部で、動脈が静脈を圧迫して静脈閉塞が起き、破綻性の出血を起こす病気です。視神経内で静脈が閉塞する網膜中心静脈閉塞症と、網膜内の静脈が閉塞する網膜静脈分枝閉塞症があります。
動脈硬化、高血圧、糖尿病、貧血などのある方は発症する危険が大きいです。
動脈硬化、高血圧、糖尿病、貧血などのある方は発症する危険が大きいです。

・網膜静脈閉塞症の症状
静脈の閉塞した部位、程度により、無症状から重い視力低下まで様々です。
眼底出血や網膜浮腫が黄斑におよぶと(黄斑浮腫)、視力低下やゆがみを生じます。
眼底出血や網膜浮腫が黄斑におよぶと(黄斑浮腫)、視力低下やゆがみを生じます。
・網膜静脈閉塞症の検査
①眼底検査
網膜の血管の状態、出血や浮腫の状態を見ることができます。
網膜の血管の状態、出血や浮腫の状態を見ることができます。

②蛍光眼底造影
フルオレセインという蛍光色素の入った造影剤を腕の静脈から注入し、眼底カメラで網膜の血管を観察します。
血管の形状、血管からの漏出、網膜の虚血などがわかります。
フルオレセインという蛍光色素の入った造影剤を腕の静脈から注入し、眼底カメラで網膜の血管を観察します。
血管の形状、血管からの漏出、網膜の虚血などがわかります。

③光干渉断層計(OCT)検査
網膜の層構造を断面的に観察でき、黄斑浮腫の状態がわかります。
網膜の層構造を断面的に観察でき、黄斑浮腫の状態がわかります。
④光干渉断層血管撮影(OCT angiography:OCTA)検査
光干渉断層画像から、造影剤を使わず非侵襲的に血管構造を画像化することができるようになりました。さらに層別に表示することができます。
光干渉断層画像から、造影剤を使わず非侵襲的に血管構造を画像化することができるようになりました。さらに層別に表示することができます。

・網膜静脈閉塞症の治療
①レーザー光凝固
虚血(毛細血管の閉塞)、新生血管が発生しているときには、悪化を防ぐために光凝固を行います。網膜浮腫を抑える目的で光凝固を行うこともあります。
虚血(毛細血管の閉塞)、新生血管が発生しているときには、悪化を防ぐために光凝固を行います。網膜浮腫を抑える目的で光凝固を行うこともあります。
②抗VEGF療法
網膜静脈閉塞症に伴う黄斑浮腫には、VEGFという物質が関与しています。そのため、VEGFの働きを抑える薬を硝子体注射し、黄斑浮腫を治療します。
網膜静脈閉塞症に伴う黄斑浮腫には、VEGFという物質が関与しています。そのため、VEGFの働きを抑える薬を硝子体注射し、黄斑浮腫を治療します。
③ステロイド療法
炎症を抑える作用があるステロイド薬を注射して、黄斑浮腫を抑えます。
炎症を抑える作用があるステロイド薬を注射して、黄斑浮腫を抑えます。
④硝子体手術
硝子体出血や網膜剥離が生じている場合には、硝子体手術を行います。ほかの治療法で充分な効果が見られないときには硝子体手術を行うこともあります。
硝子体出血や網膜剥離が生じている場合には、硝子体手術を行います。ほかの治療法で充分な効果が見られないときには硝子体手術を行うこともあります。
Copyright(C)okushiba_eyeclinic_All Rights Reserved.
